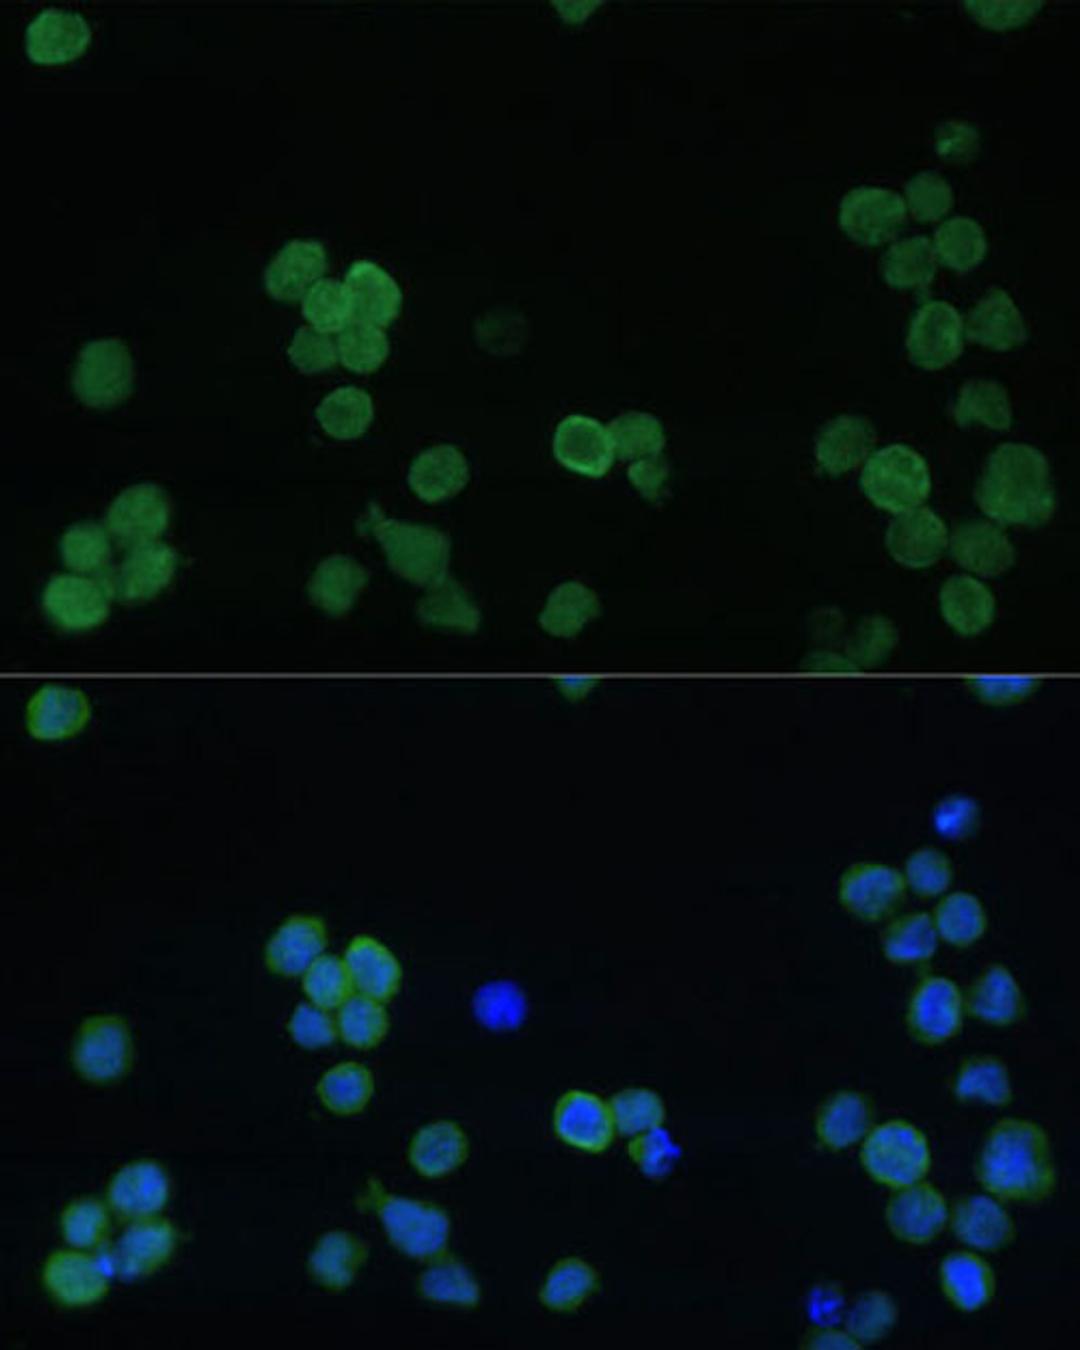
Immunofluorescence - GP1BA Polyclonal Antibody (A16048)
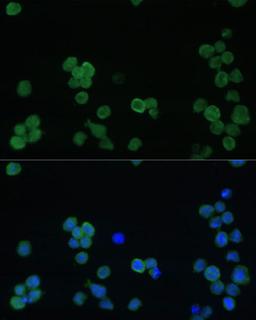
Immunofluorescence - GP1BA Polyclonal Antibody (A16048)
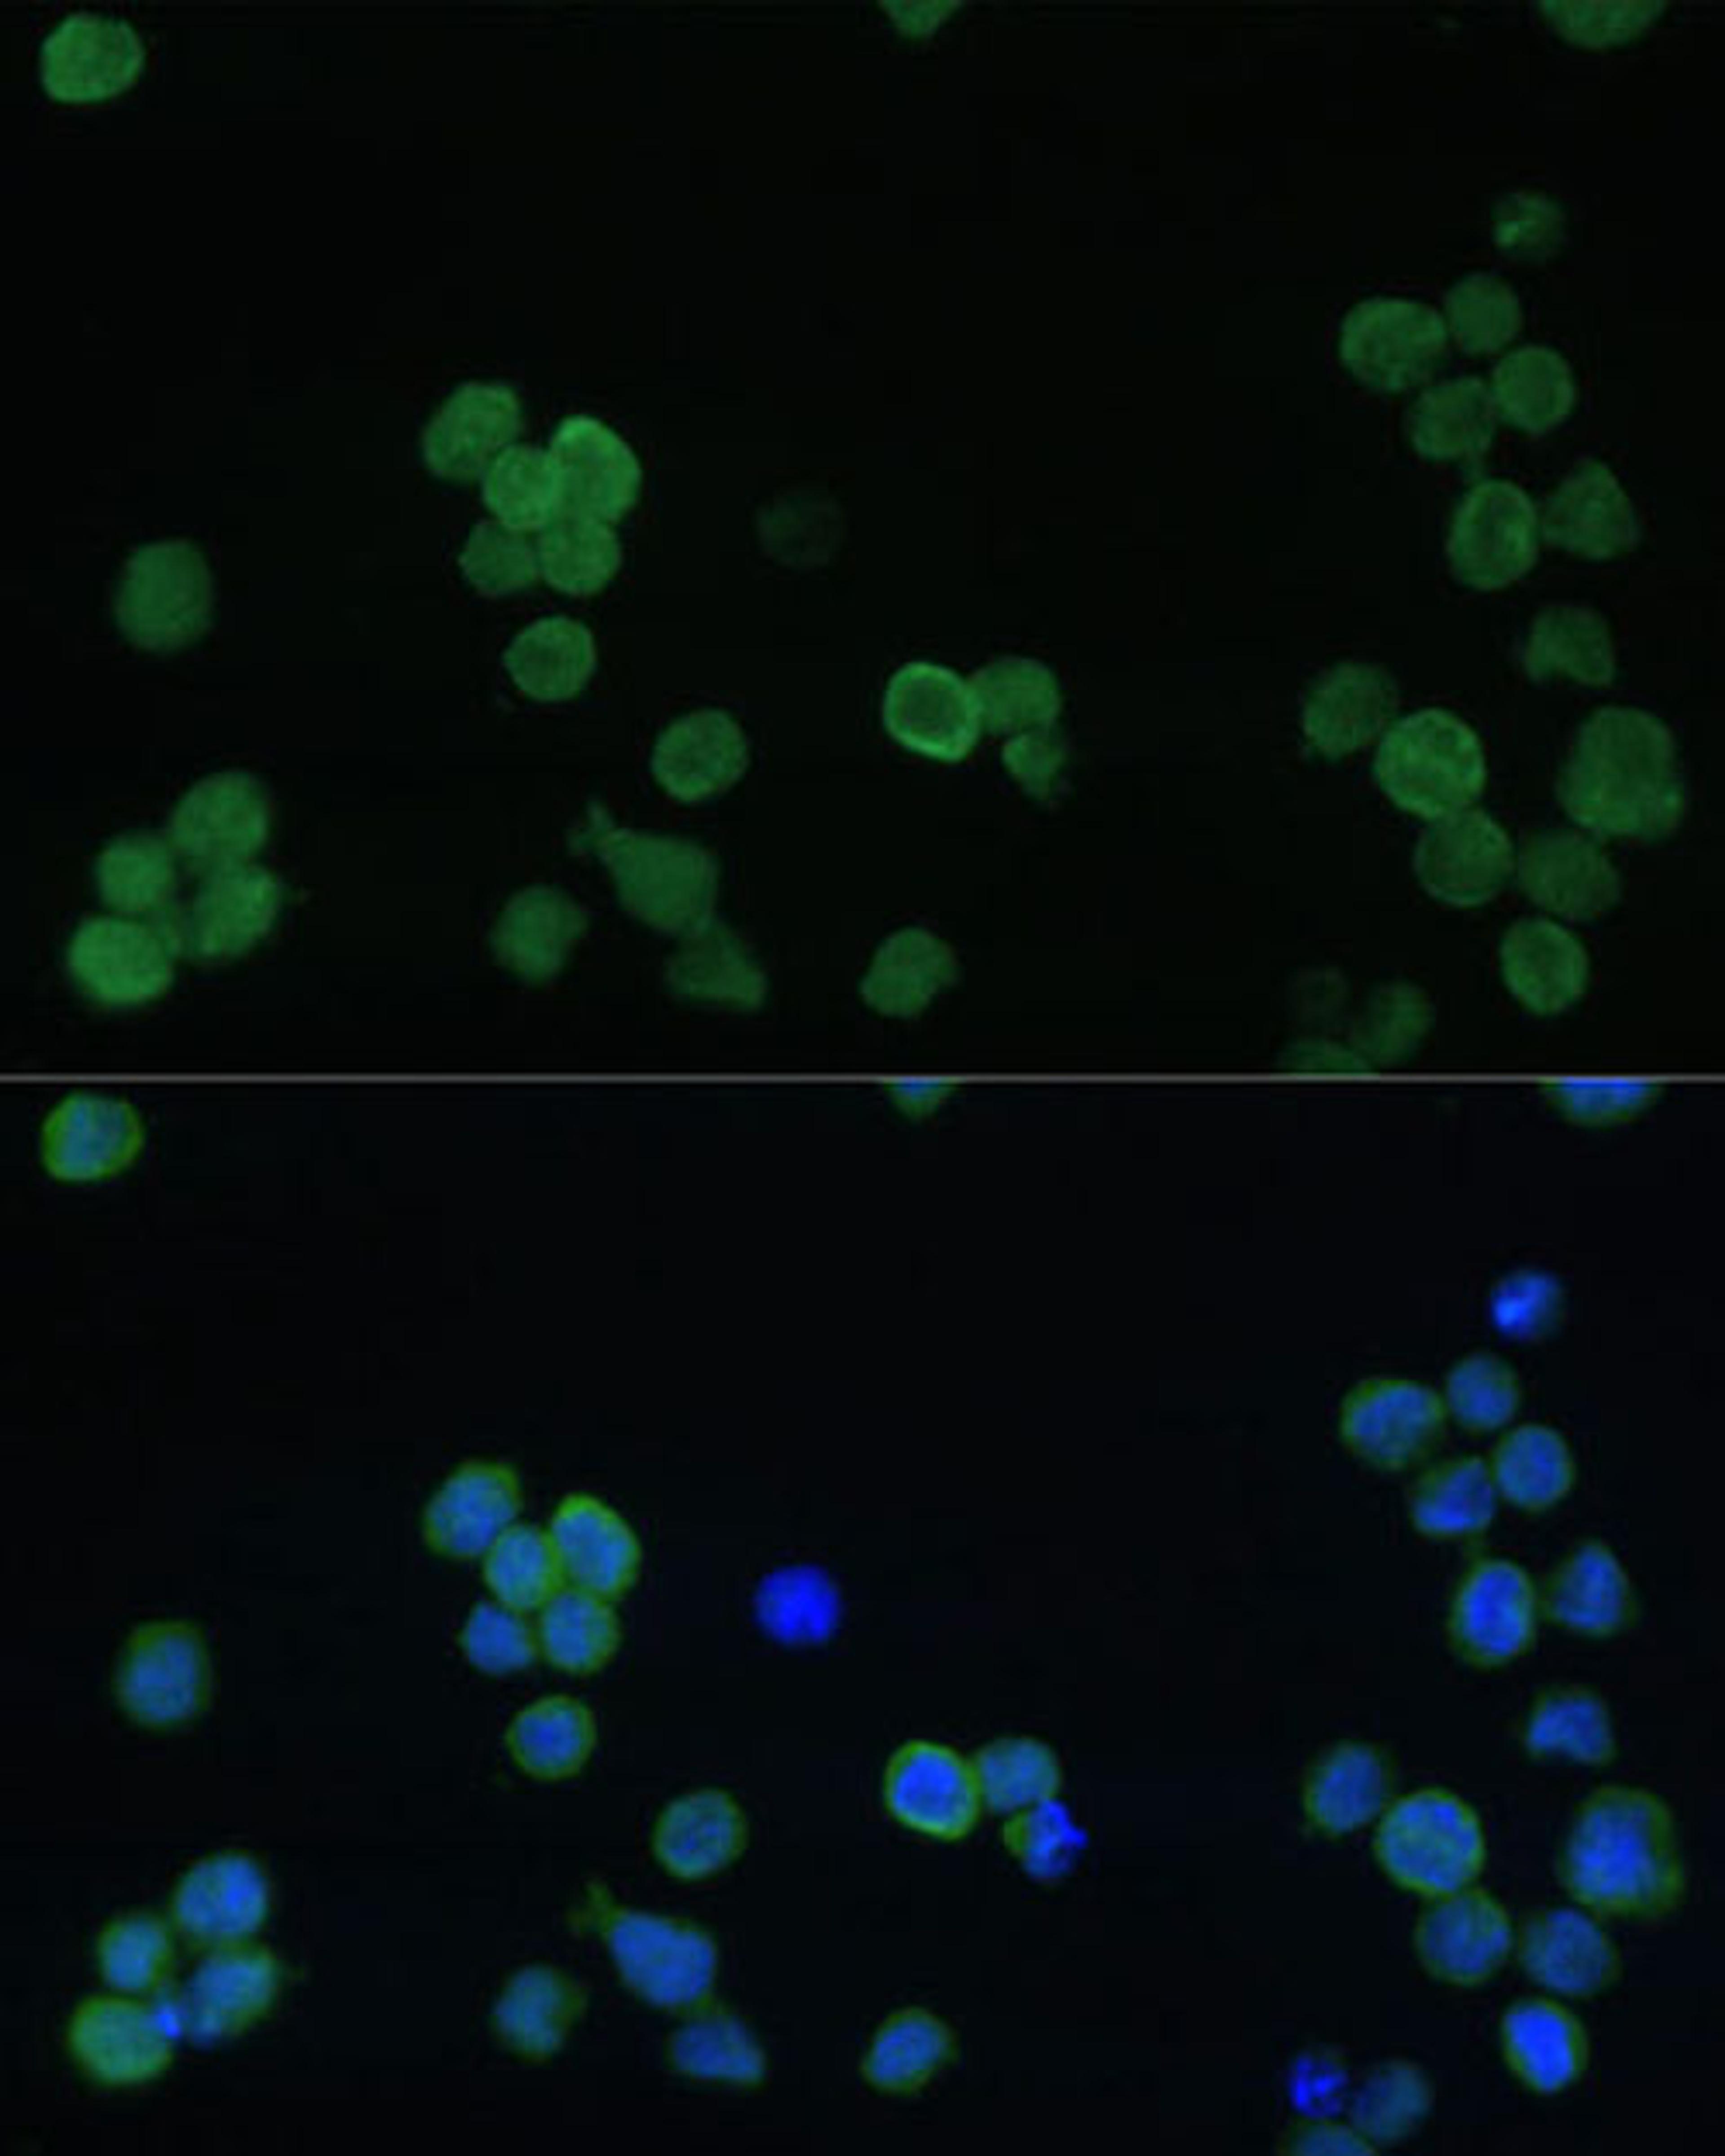
Immunofluorescence - GP1BA Polyclonal Antibody (A16048)

GP1BA Rabbit pAb
Product Details
- Cat. No.
- A16048
- Type
- Primary Antibody
- Clonality
- Polyclonal
- Host
- Rabbit

The supplier does not provide quotations for this antibody through SelectScience. You can search for similar antibodies in our Antibody Directory.
Description
Glycoprotein Ib (GP Ib) is a platelet surface membrane glycoprotein composed of a heterodimer, an alpha chain and a beta chain, that is linked by disulfide bonds. The Gp Ib functions as a receptor for von Willebrand factor (VWF). The complete receptor complex includes noncovalent association of the alpha and beta subunits with platelet glycoprotein IX and platelet glycoprotein V. The binding of the GP Ib-IX-V complex to VWF facilitates initial platelet adhesion to vascular subendothelium after vascular injury, and also initiates signaling events within the platelet that lead to enhanced platelet activation, thrombosis, and hemostasis. This gene encodes the alpha subunit. Mutations in this gene result in Bernard-Soulier syndromes and platelet-type von Willebrand disease. The coding region of this gene is known to contain a polymophic variable number tandem repeat (VNTR) domain that is associated with susceptibility to nonarteritic anterior ischemic optic neuropathy.
Biological Information
- Clonality: Polyclonal
- Host: Rabbit
- Reactivity: Human